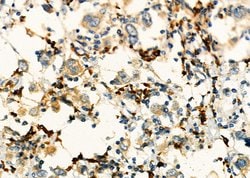
Invitrogen KIF4A Polyclonal Antibody 100 &mu;L; Unconjugated:Antibodies,

missing translation for 'onlineSavingsMsg'
Learn More
Learn More
Invitrogen™ KIF4A Polyclonal Antibody


Rabbit Polyclonal Antibody
Brand: Invitrogen™ PA5115469
This item is not returnable.
View return policy
Description
Antibody detects endogenous levels of total KIF4A.
This gene encodes a member of the kinesin 4 or subfamily of kinesin related proteins. This subfamily is also referred to as the chromokinesins. The encoded protein is an ATP dependent microtubule-based motor protein that is involved in the intracellular transport of membranous organelles. This protein also associates with condensed chromosome arms and may be involved maintaining chromosome integrity during mitosis. This protein may also be involved in the organization of the central spindle prior to cytokinesis. A pseudogene of this gene is found on chromosome X.
Specifications
| KIF4A | |
| Polyclonal | |
| Unconjugated | |
| Kif4a | |
| AI323435; Chromokinesin; chromokinesin-A; Chromosome-associated kinesin KIF4; chromosome-associated kinesin KIF4A; D330050K22Rik; FLJ12530; FLJ12655; FLJ14204; FLJ20631; HSA271784; KIF4; KIF4A; KIF4G1; KIF4-G1; kinesin family member 4; kinesin family member 4A; kinesin heavy chain member 4; Kns4; MRX100; N-5 kinesin | |
| Rabbit | |
| Affinity Chromatography | |
| RUO | |
| 24137 | |
| -20°C | |
| Liquid |
| Immunohistochemistry (Paraffin), Western Blot, Immunocytochemistry | |
| 1 mg/mL | |
| PBS with 50% glycerol and 0.02% sodium azide | |
| O95239 | |
| Kif4a | |
| A synthesized peptide derived from human KIF4A(Accession O95239), corresponding to amino acid residues Y1200-H1232. | |
| 100 μL | |
| Primary | |
| Human | |
| Antibody | |
| IgG |
Product Content Correction
Your input is important to us. Please complete this form to provide feedback related to the content on this product.
Product Title
Spot an opportunity for improvement?Share a Content Correction